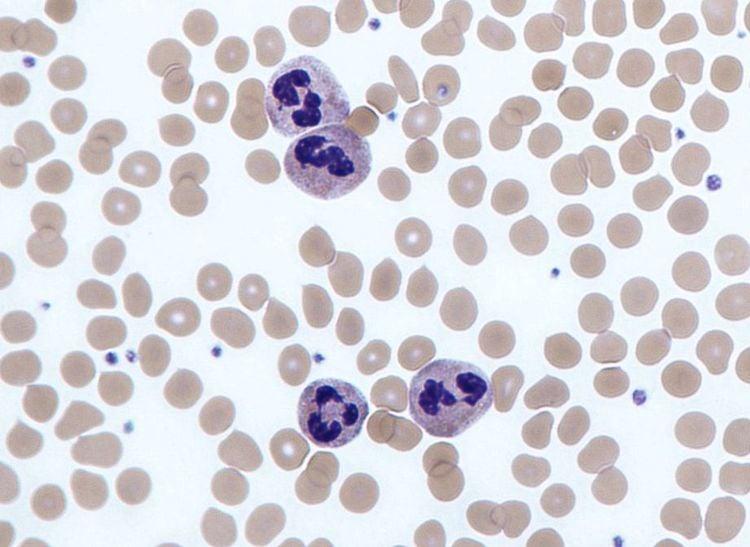
Bạch cầu trung tính là gì? Vì sao bạch cầu trung tính giảm

Ý nghĩa Hoa Cúc Vạn Thọ: Mang đến điềm lành trong cuộc sống - FLoLi
Hoa cúc vạn thọ vô cùng quen thuộc đối với mỗi con người chúng ta, đặc biệt là vào dịp rằm, đầu tháng, cuối tháng hoặc lễ Tết không thể nào thiếu hình dáng của loài hoa này. Hoa mang...
Soạn bài Hang Én - Kết nối tri thức 6 Ngữ văn lớp 6 trang 114 sách Kết nối tri thức tập 1
Văn bản Hang Én sẽ được giới thiệu đến các bạn học sinh trong sách Ngữ Văn lớp 6, thuộc sách Kết nối tri thức, tập 1. Soạn bài Hang Én Download.vn sẽ cung cấp tài liệu...
Trở thành hay chở Thành là đúng chính tả?
Trở thành hay chở thành, cách viết nào đúng và có ý nghĩa trong tiếng Việt? Rất nhiều người vẫn thường nhầm lẫn giữa trở và chở vì cách phát âm tương đồng của chúng, hãy để Văn VN check...
News
Tháng 06 năm 2025, cộng đồng người Việt Georgia đã chứng kiến sự lớn mạnh và lan tỏa tình thương của một ngôi nhà đặc biệt mang tên First Senior Center (FSC). Hành trình tám năm ấy là minh chứng...
Chùm thơ buồn sâu lắng bày tỏ nỗi niềm về cuộc sống
Tìm đến thơ buồn, người ta thấy được sự đồng điệu về cảm xúc. Có những lúc cảm xúc chùng xuống những câu chữu thông thường không thể tả hết nỗ lòng. Nếu “lòng đang dậy sóng”, hãy tìm đến...
Những tác phẩm Nguyễn Trung Thành (Nguyễn Ngọc) hay nhất
Các tác phẩm Nguyễn Trung Thành hay Nguyễn Ngọc mang đậm âm hưởng sử thi và không kém phần lãng mạn. Hầu hết các tác phẩm của ông đều là văn xuôi viết về chủ đề núi rừng Tây Nguyên....
Tổng hợp ca dao, tục ngữ, thành ngữ về tinh thần trách nhiệm
Văn VN cập nhật những câu ca dao tục ngữ về tinh thần trách nhiệm cùng những thành ngữ, danh ngôn nói hay. Đây là góc nhìn, những nhận xét, đánh giá, kinh nghiệm của ông bà ta về việc...
Giải bài tập Tiếng Việt 1 trang 60, 61 Bài 6: Giờ ra chơi
Giải bài tập Tiếng Việt 1 trang 60, 61 Bài 6: Giờ ra chơi gồm có phần phần yêu cầu, phần đáp án chuẩn và phần giải thích, hướng dẫn chi tiết cho từng câu hỏi có trong cuốn Sách...
Cambodia’s Dirty Dozen
Under Prime Minister Hun Sen, Cambodia is in a human rights freefall. Despite the strong human rights provisions in the 1991 Paris Peace Agreements and the 1993 constitution—and billions of dollars in development aid, including a plethora of technical assistance...
Bạch cầu trung tính là gì? Vì sao bạch cầu trung tính giảm
Bạch cầu là một trong các thành phần tế bào của máu có chức năng miễn dịch nhằm bảo vệ cơ thể chống lại sự xâm nhập của các tác nhân như vi khuẩn, virus, ký sinh trùng,... Bên cạnh...
Xuân về trên các tuyến hẻm “Dân vận khéo”
Năm 2024, phong trào thi đua “Dân vận khéo” trên địa bàn Quận 4 tiếp tục được các cơ quan, đơn vị thực hiện có hiệu quả, thiết thực, tạo sức lan tỏa sâu rộng, được đông đảo cán bộ,...
Thà là ô thước xin đừng cách biệt âm dương nghĩa là gì?
Câu nói “Thà là ô thước xin đừng cách biệt âm dương” thể hiện nỗi đau đớn, tiếc nuối khôn nguôi khi vĩnh viễn mất đi người mình yêu thương. Nó mang ý nghĩa mong muốn được hóa thành loài...
Bài phân tích đoạn 2 Tây Tiến hay nhất
Tuyển chọn những bài văn mẫu hay chủ đề phân tích đoạn 2 Tây Tiến. Các bài văn mẫu được biên soạn tổng hợp chi tiết, đầy đủ từ các bài viết hay, xuất sắc nhất của các bạn học...